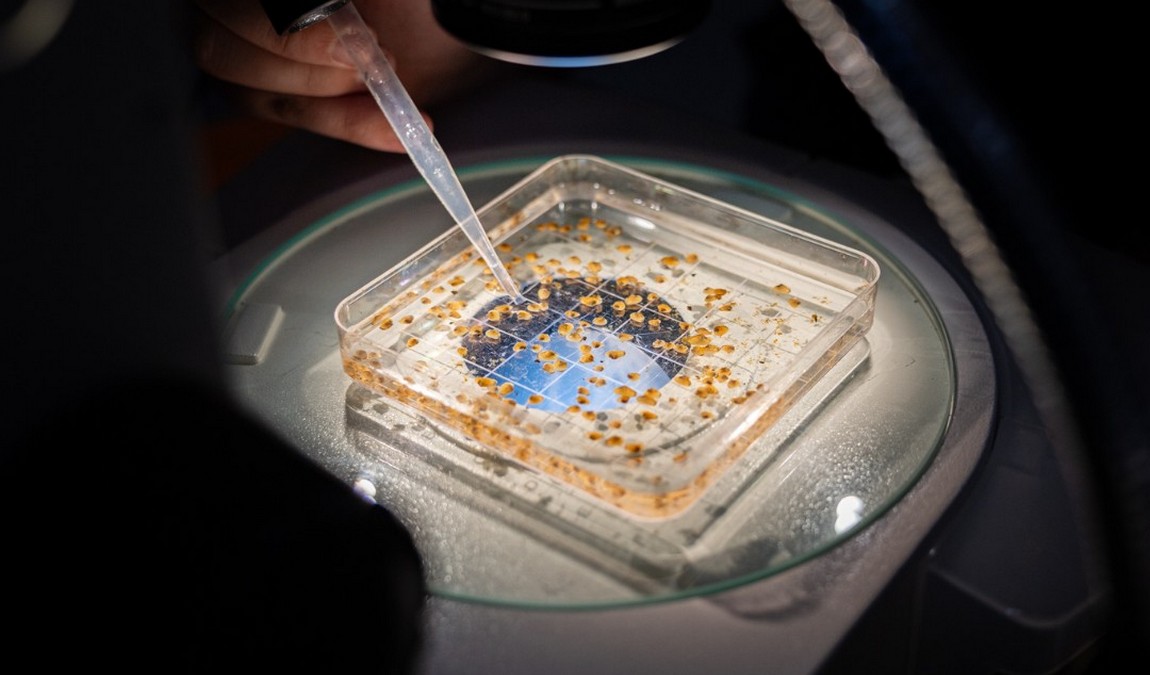
greensboro science center photo 2

The Greensboro Science Center is a dynamic destination that combines education, adventure, and fun under one roof. It is located in the heart of North Carolina and offers a unique blend of a science museum, zoo, and aquarium. It is a perfect spot for families looking to explore and learn together. With many interactive exhibits and engaging programs, the center captivates visitors of all ages. Whether you're a local or just passing through, the Greensboro Science Center promises an unforgettable experience that will spark curiosity and inspire young minds. Dive into the wonders of science and nature and discover why this center is a must-visit for families.
Highlights
- Wiseman Aquarium: Dive into marine wonders with sharks and penguins.
- Science Museum: Explore the Dinosaur Room and Extreme Weather Gallery.
- Zoo: Meet exotic animals like tigers, red pandas, and lemurs.
Contents
 Photo: facebook.com/GreensboroScienceCenter
Photo: facebook.com/GreensboroScienceCenter
Here is Why Your Kids Will Find it Interesting
Greensboro Science Center is worth visiting with kids because it offers a world of discovery tailored for young explorers. Children aged 3 to 12 will be especially fascinated by the interactive exhibits and hands-on experiences. From touching stingrays in the aquarium to exploring the prehistoric world of dinosaurs, there's something to ignite every child's imagination. The center's engaging and educational environment ensures that learning is always fun.
Family-friendly Features
- Interactive Exhibits: Hands-on activities throughout the center engage children in active learning.
- Cafeteria and Picnic Areas: Convenient dining options for families.
- Sensory-Friendly Nights: Special events designed for children with sensory sensitivities.
History and Background
Photo: facebook.com/GreensboroScienceCenter
Photo: facebook.com/GreensboroScienceCenter
Founded in 1957, the Greensboro Science Center has grown from a modest museum to a multifaceted institution. Over the decades, it has expanded to include a zoo, aquarium, and an OmniSphere Theater, making it a comprehensive educational facility. Key milestones include the addition of the Wiseman Aquarium and the launch of the SkyWild ropes course, both of which have significantly enhanced the visitor experience.
Main Attractions
Wiseman Aquarium
 Photo: greensboroscience.org
Photo: greensboroscience.org
The Wiseman Aquarium at the Greensboro Science Center is a captivating marine haven that draws visitors into the mesmerizing world of aquatic life. As you step into the aquarium, you're greeted by a vibrant display of marine ecosystems, each teeming with life and color. The highlight for many is the Shark Reef, a massive 90,000-gallon Caribbean habitat that houses a variety of aquatic creatures, including formidable sharks, graceful rays, and curious moray eels. This exhibit offers a rare glimpse into the underwater world, where visitors can watch these majestic creatures glide effortlessly through the water.
The touch tanks are one of the most engaging features of the Wiseman Aquarium. These interactive exhibits allow visitors to gently interact with marine life, such as stingrays and horseshoe crabs, providing a tactile connection to the ocean's wonders. The touch tanks are particularly popular with children, who delight in feeling a stingray's smooth skin or the crab's hard shell. This hands-on experience is educational and thrilling, making it a must-visit spot within the aquarium.
For those looking to enhance their visit, arriving early is advisable. This helps avoid the larger crowds and allows visitors to catch the scheduled feeding times. Watching the feeding is a fascinating experience, as it offers insight into the behaviors and diets of the aquarium's residents. Additionally, the aquarium hosts daily programs and displays that provide further educational opportunities, ensuring that every visit is informative and entertaining.
The Wiseman Aquarium also boasts a delightful colony of African penguins. These charismatic birds are a favorite among visitors, and the Inside Tracks program offers a unique opportunity to learn about penguin conservation and management. Participants in this program can enjoy a 45-minute session that includes meeting some of the penguins and understanding the efforts involved in their care.
Overall, the Wiseman Aquarium is more than just a place to observe marine life; it's an immersive experience that educates and inspires. Whether you're marveling at the sharks, gently touching a stingray, or learning about penguin conservation, the aquarium offers a rich tapestry of experiences that bring the ocean's mysteries to life.
Science Museum
 Photo: greensboroscience.org
Photo: greensboroscience.org
The Science Museum at the Greensboro Science Center is a treasure chest of knowledge and discovery, offering visitors an immersive dive into natural history and scientific phenomena. As you step inside, you're immediately transported to a world where dinosaurs roam and weather patterns come alive. The Dinosaur Room is a standout feature, captivating guests with its life-sized models, including a towering 36-foot Tyrannosaurus Rex. This exhibit showcases the grandeur of these prehistoric giants and educates visitors about their habitats and behaviors through interactive displays and fossil replicas.
Equally enthralling is the Extreme Weather Gallery, where the forces of nature are vividly illustrated. Here, visitors can experience the raw power of tornadoes, hurricanes, and other extreme weather events through engaging simulations and multimedia presentations. This gallery provides a unique opportunity to understand the science behind these natural phenomena, making it a favorite among children and adults.
For young explorers, the museum offers SciPlay Bay, an interactive play space designed to make learning fun and accessible. This area has hands-on activities encouraging children to experiment and explore various scientific concepts. Kids Alley complements this experience by offering interactive exhibits that focus on different scientific principles, ensuring that learning is engaging and enjoyable.
Overall, it is a vibrant hub of learning and exploration where visitors of all ages can delve into the wonders of science and nature. Whether you're uncovering the secrets of the dinosaurs, braving the elements in the Extreme Weather Gallery, or engaging in hands-on activities in SciPlay Bay, the museum promises a day of discovery and delight.
Zoo
 Photo: greensboroscience.org
Photo: greensboroscience.org
The zoo at the Greensboro Science Center is a vibrant tapestry of wildlife, offering visitors an intimate glimpse into the lives of animals from around the globe. As you wander through the lush pathways, you'll encounter a diverse array of creatures with unique stories and charm. Among the most majestic residents are the Sumatran tigers, whose striking stripes and powerful presence captivate all who pass by. These endangered cats are part of the center's conservation efforts, and visitors can learn about the challenges they face in the wild and the initiatives in place to protect them.
Equally enchanting are the red pandas, with their fiery fur and playful antics. These arboreal animals delight guests as they navigate their treetop habitats, showcasing their agility and curious nature. The zoo's lemurs add to the exotic appeal, with their expressive eyes and social behaviors providing endless entertainment. These primates, native to Madagascar, are a testament to the center's commitment to preserving biodiversity and educating the public about the importance of conservation.
For a more hands-on experience, the petting zoo offers a delightful opportunity for children to interact with friendly farm animals. Here, kids can feed and pet goats, sheep, and other domesticated animals fostering a connection with nature and an appreciation for animal care. This interactive setting is perfect for young visitors, providing a safe and engaging environment to learn about the responsibilities of animal husbandry.
The reptile house is another highlight, home to a fascinating collection of snakes, lizards, and turtles. This exhibit allows visitors to observe these misunderstood creatures up close, with informative displays highlighting their ecological roles and adaptations. From the vibrant scales of a boa constrictor to a tortoise's slow, deliberate movements, the reptile house offers a captivating look at the diversity of reptilian life.
Throughout the zoo, educational signage and interactive displays provide insights into the natural behaviors and habitats of the animals, encouraging visitors to think critically about wildlife conservation. The zoo's design emphasizes naturalistic enclosures, ensuring the animals have ample space to roam and express their natural behaviors while providing visitors with an immersive and educational experience.
OmniSphere Theater
- Types of Shows: The theater offers a variety of 3D and full-dome experiences that transport visitors to different worlds.
- Schedule and Ticketing: Check the schedule and purchase tickets early to secure your spot for popular shows.
Unique Experiences
SkyWild
 Photo: greensboroscience.org
Photo: greensboroscience.org
- Overview: This outdoor ropes course offers thrilling challenges above the zoo, providing a bird's-eye view of the surroundings.
- Age and Safety Requirements: Suitable for ages 8 and up, with safety harnesses for all participants.
Inside Tracks Program
- Details: This program offers behind-the-scenes animal encounters and educational sessions, allowing visitors to learn directly from the experts.
Best Time to Visit
 Photo: greensboroscience.org
Photo: greensboroscience.org
The best time to visit with children is on weekdays in the morning when the center is less crowded. Aim for a visit during spring or fall for pleasant weather. Recommended duration: Spend at least half a day exploring all attractions fully.
Our Resume
The Greensboro Science Center offers a perfect blend of education and entertainment, making it an ideal destination for families. Its diverse attractions and engaging programs promise a day of discovery and fun for children and adults alike.








